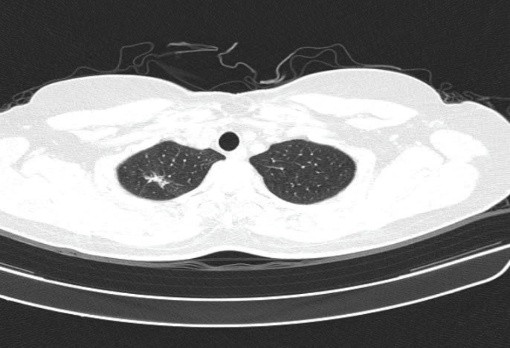

Ca lâm sàng:
Điều trị hóa chất kết hợp liệu pháp miễn dịch ở bệnh nhân ung thư phổi không tế bào nhỏ giai đoạn IV tại Trung tâm Y học hạt nhân và Ung bướu – Bệnh viện Bạch Mai
GS.TS Mai Trọng Khoa, BSNT. Vũ Mạnh Cường, PGS.TS Phạm Cẩm Phương, Ths. Trần Văn Oai
Trung tâm Y học hạt nhân và Ung bướu – Bệnh viện Bạch Mai
Trường Đại học Y Dược – Đại học Quốc Gia Hà Nội
Ung thư phổi là loại ung thư phổ biến và là nguyên nhân gây tử vong do ung thư thường gặp cnhất trên thế giới trong nhiều thập kỷ qua. Theo số liệu từ GLOBOCAN 2022, ung thư phổi đứng thứ hai về số ca mắc mới với khoảng 2,5 triệu trường hợp mỗi năm và là nguyên nhân hàng đầu gây tử vong do ung thư với hơn 1,8 triệu ca tử vong. Tại Việt Nam, ung thư phổi đứng thứ hai về số ca mắc mới và đứng hàng đầu về tử vong do ung thư trong năm 2022.
Ung thư phổi không tế bào nhỏ chiếm khoảng 80–85% các trường hợp ung thư phổi. Do bệnh thường tiến triển âm thầm, phần lớn bệnh nhân được chẩn đoán ở giai đoạn tiến xa, khi các phương pháp điều trị triệt căn không còn phù hợp và điều trị toàn thân giữ vai trò chủ đạo. Trong nhiều năm, hóa trị nền platinum là tiêu chuẩn điều trị cho bệnh nhân ung thư phổi không tế bào nhỏ giai đoạn IV không có đột biến gen đích, tuy nhiên hiệu quả còn hạn chế.
Trong những năm gần đây, cùng với sự ra đời của liệu pháp miễn dịch ức chế điểm kiểm soát miễn dịch, pembrolizumab, một kháng thể đơn dòng kháng PD-1, đã trở thành một lựa chọn điều trị quan trọng trong ung thư phổi không tế bào nhỏ giai đoạn tiến xa thông qua việc ức chế trục PD-1/PD-L1 và phục hồi đáp ứng miễn dịch qua trung gian tế bào T chống lại tế bào ung thư. Phù hợp với cơ chế tác dụng này, nghiên cứu KEYNOTE-189 cho thấy việc phối hợp pembrolizumab với hóa chất nền platinum trong điều trị bước một ung thư phổi không tế bào nhỏ thể biểu mô tuyến giúp cải thiện có ý nghĩa thống kê tỷ lệ đáp ứng, thời gian sống không tiến triển và thời gian sống còn toàn bộ so với hóa trị đơn thuần, bất kể mức biểu hiện PD-L1.
Sau đây chúng tôi xin giới thiệu một trường hợp lâm sàng: bệnh nhân bệnh nhân ung thư phổi không tế bào nhỏ giai đoạn IV thể biểu mô tuyến được điều trị bước một bằng pembrolizumab kết hợp hóa chất, tại Trung tâm Y học hạt nhân và ung bướu – Bệnh viện Bạch Mai
Họ và tên: LUU L. H Giới: Nữ Tuổi: 53
Nghề nghiệp: Nhân viên văn phòng
Ngày vào viện: 03/12/2024
Lý do vào viện: sờ thấy hạch cổ phải
Bệnh sử: Cách vào viện 01 tháng, bệnh nhân sờ thấy hạch cổ bên phải kích thước khoảng 1cm, cứng chắc, ít di động, sờ đau nhẹ. Bệnh nhân không sốt, không ho, không đau tức ngực, không đau đầu, không đau xương, không gầy sút cân, đại tiểu tiện bình thường. Bệnh nhân đi khám được siêu âm hạch cổ cho kết quả hình ảnh nghi ngờ, chọc tế bào tổn thương hạch cổ phải cho kết quả Ung thư biểu mô di căn. Bệnh nhân được chuyển Trung tâm Y học hạt nhân và Ung bướu, Bệnh viện Bạch Mai điều trị.
Tiền sử:
– Bản thân: khỏe mạnh
– Gia đình: Chưa ghi nhận bệnh lý liên quan
Khám lâm sàng:
Bệnh nhân tỉnh; tiếp xúc tốt
Toàn trạng PS 0
Huyết động ổn định
Da niêm mạc hồng
Không sốt
Không đau tức ngực
Hạch thượng đòn 2 bên, kích thước khoảng 1-2 cm; cứng chắc; di động kém; ấn đau nhẹ
Tim đều, T1 T2 rõ
Phổi thông khí được, không rales
Bụng mềm, không chướng
Các cơ quan khác chưa phát hiện bất thường
Cận lâm sàng:
– Công thức máu: Hồng cầu: 4,3T/L; Hb: 133 g/l; Bạch cầu: 7,28 G/L; Tiểu cầu: 422 G/L (trong giới hạn bình thường)
– Sinh hóa máu: Creatinin: 61μmol/l; AST 44 U/L; ALT: 21 U/L (trong giới hạn bình thường)
– Chất chỉ điểm khối u (Tumor marker): CEA: 0,9 ng/mL (trong giới hạn bình thường), Cyfra 21-1: 4.03 ng/mL (tăng nhẹ)
– Siêu âm hạch cổ: hạch bất thường thượng đòn 2 bên kích thước 8x15mm; không rõ cấu trúc rốn hạch
– Chụp cắt lớp vi tính lồng ngực: Nhu mô thùy trên phổi (Phải) có nốt tổn thương kích thước 13x14mm, bờ không đều, ngấm thuốc, sau tiêm. Rải rác nốt đặc 2 bên thùy phổi kích thước 3-10mm. Trung thất các nhóm 1R; 2R; 4R; 5; 8; 10RL có vài hạch lớn nhất kích thước 26x15mm; bờ không đều; ngấm thuốc không đồng nhất sau tiêm. Thượng đòn 2 bên có vài hạch tính chất tương tự; hạch bên phải kích thước 11x14mm
Hình 1. Hình ảnh cắt lớp vi tính ngực có tiêm: thùy trên phổi (P) có nốt tổn thương kích thước 13x14mm, bờ không đều, ngấm thuốc, sau tiêm. Nghi ngờ tổn thương nguyên phát (mũi tên đỏ)

Hình 2: Hình ảnh cắt lớp vi tính ngực có tiêm: Rải rác nốt đặc 2 bên thùy phổi kích thước 3-10mm (các mũi tên màu xanh lá)

Hình 3: Hình ảnh cắt lớp vi tính ngực có tiêm: Trung thất các nhóm 1R; 2R; 4R; 5; 8; 10RL có vài hạch lớn nhất kích thước 26x15mm; bờ không đều; ngấm thuốc không đồng nhất sau tiêm (mũi tên màu cam)
– Cắt lớp vi tính ổ bụng:

Hình 4: Hình ảnh cắt lớp vi tính ổ bụng có tiêm: chưa phát hiện tổn thương nghi ngờ thứ phát
– Cộng hưởng từ sọ não:
Hình 5: Hình ảnh cộng hưởng từ sọ não: chưa phát hiện tổn thương thứ phát
– Xạ hình xương: chưa phát hiện tổn thương xương trên xạ hình xương toàn thân
– Nội soi dạ dày – đại tràng: bình thường
– Siêu âm tim: kích thước và chức năng tâm thu thất trái trong giới hạn bình thường.
– Điện tim: nhịp xoang, trục trung gian, tần số 61 lần/phút
– Sinh thiết hạch thượng đòn phải dưới hướng dẫn của siêu âm cho kết quả:
Giải phẫu bệnh: Ung thư biểu mô di căn hạch
Hóa mô miễn dịch: Hình hình ảnh mô bệnh học và hóa mô miễn dịch phù hợp với ung thư biểu mô tuyến phổi di căn hạch; PDL-1 dương tính, TPS = 95%; EGFR (-); ALK (-)
Chẩn đoán xác định: Ung thư biểu mô tuyến thùy trên phổi phải, cT1N3M1 di căn phổi; EGFR (-), ALK (-), PD-L1 dương tính 95%.
Bệnh nhân được hội chẩn hội đồng đa chuyên khoa (Multidisciplinary Team – MDT) với sự tham gia của các bác sĩ chuyên ngành Ung bướu, phẫu thuật lồng ngực, chẩn đoán hình ảnh và giải phẫu bệnh. Kết luận bệnh nhân có chỉ định điều trị miễn dịch kết hợp hóa chất phác đồ Pemetrexed – Carboplatin – Pembrolizumab. Đánh giá sau mỗi 03 chu kỳ
Phác đồ Pemetrexed – Carboplatin – Pembrolizumab chu kì 21 ngày:
Carboplatin AUC 5 truyền TM ngày 1
Pemetrexed 500mg/m2, truyền TM ngày 1.
Pembrolizumab 200mg, pha truyền TM ngày 1.
Bệnh nhân hoàn thành 3 chu kỳ hóa chất thuận lợi, gặp một số tác dụng phụ như mệt mỏi, buồn nôn, chán ăn sau truyền, các triệu chứng mệt mỏi và buồn nôn này giảm dần sau 3-4 ngày. Chúng tôi bổ sung acid folic và vitamin B12 trong suốt quá trình điều trị, theo dõi kết quả xét nghiệm máu ở mỗi đợt điều trị, các chỉ số hồng cầu, bạch cầu, tiểu cầu đều trong giới hạn bình thường.
Đánh giá sau 03 chu kỳ Pemetrexed – Carboplatin – Pembrolizumab:
– Về lâm sàng: bệnh nhân không đau ngực, không khó thở, không gầy sút cân, làm việc và sinh hoạt bình thường
– Chất chỉ điểm khối u (Tumor marker): CEA: 1.29 ng/mL, Cyfra 21-1: 2.28 ng/ml (giảm về giá trị trong khoảng bình thường).
– Siêu âm hạch cổ: hạch cổ hai bên vài hạch đường kính 3-5mm
– Cắt lớp vi tính lồng ngực: đám xẹp đông đặc đỉnh phổi phải kích thước 11mm; nhu mô phổi rải rác nốt đặc 5-10mm. Trung thất cân đối có vài hạch 10mm
Hình 6: Hình ảnh cắt lớp vi tính ngực có tiêm: đám xẹp đông đặc đỉnh phổi phải kích thước 11mm (mũi tên xanh nước biển)
Hình 7: Hình ảnh cắt lớp vi tính ngực có tiêm: Trung thất cân đối có vài hạch 10mm (mũi tên vàng). Hạch trung thất giảm kích thước rất nhiều chỉ sau 03 chu kỳ.
– Cắt lớp vi tính ổ bụng: Không phát hiện tổn thương bất thường.
– Cộng hưởng từ sọ não: Không phát hiện tổn thương bất thường.
Đánh giá sau 06 chu kỳ Pemetrexed – Carboplatin – Pembrolizumab
PET CT: Hình ảnh nốt mờ bờ tua gai vùng đỉnh phổi phải kích thước 9x12mm; không tăng chuyển hóa FDG. Hạch cạnh khí quản đoạn thấp kích thước 7x9mm, tăng chuyển hóa FDG (SUV max: 4.83). Chưa phát hiện hình ảnh tăng chuyển hóa FDG khu trú, bất thường tại các vị trí khác trên PET CT toàn thân

Hình 8: Hình ảnh PET CT: Hạch cạnh khí quản đoạn thấp kích thước 7x9mm, tăng chuyển hóa FDG (SUV max: 4.83). (mũi tên màu hồng)
Sau 6 chu kỳ Pemetrexed – Carboplatin – Pembrolizumab, đánh giá bệnh đáp ứng; bệnh nhân tiếp tục duy trì Pemetrexed – Pembrolizumab.
Bệnh nhân được theo dõi tác dụng phụ, đánh giá đáp ứng sau mỗi 3 chu kỳ, hiện tại sau 09 chu kỳ Pemetrexed – Pembrolizumab.
Đánh giá sau 09 chu kỳ Pemetrexed – Pembrolizumab
– Về lâm sàng: Bệnh nhân hoàn ổn định; sinh hoạt và làm việc bình thường
– Chất chỉ điểm khối u: CEA: 2,12 ng/mL, Cyfra 21-1: 1.23 ng/ml (trong khoảng bình thường).
– Siêu âm hạch cổ: không phát hiện bất thường
Hình 9: Hình ảnh siêu âm hạch cổ: không phát hiện bất thường
– Cắt lớp vi tính lồng ngực: Đám xẹp vùng đỉnh phổi phải, nốt đặc nhỏ kích thước 2-3mm. Không thấy hạch to hay khối trong trung thất
Hình 10: Hình ảnh cắt lớp vi tính ngực có tiêm: Đám xẹp vùng đỉnh phổi phải, nốt đặc nhỏ kích thước 2-3mm

Hình 11: Hình ảnh cắt lớp vi tính ngực có tiêm: Không thấy hạch to hay khối trong trung thất
– Cắt lớp vi tính ổ bụng: Không phát hiện tổn thương bất thường.
– Cộng hưởng từ sọ não: Không phát hiện tổn thương bất thường.
Bảng 1. So sánh trước và sau khi điều trị 06 chu kỳ Pemetrexed – Carboplatin – Pembrolizumab + 09 chu kỳ Pemetrexed – Pembrolizumab trên CLVT ngực
| Trước điều trị | Sau điều trị | |
|
Về tổn thương nguyên phát |
Tổn thương thùy trên phổi (P) kích thước 13x14mm, bờ không đều, ngấm thuốc, sau tiêm
|
Đám xơ xẹp vùng đỉnh phổi phải
|
|
Về tổn thương phổi |
![]() |
![]() |
| Các nốt đặc rải rác kích thước 3-10mm (mũi tên đỏ) (bên trái) đã biến mất | ||
|
Về hạch trung thất |
![]() |
![]() |
| Tổn thương hạch trung thất bên trái (mũi tên vàng) đã biến mất | ||
Nhận xét: Chỉ sau 03 chu kỳ Pemetrexed – Carboplatin – Pembrolizumab, hình ảnh chụp cắt lớp vi tính cho thấy tổn thương phổi nguyên phát và các hạch giảm kích thước đáng kể. Đáp ứng điều trị được đánh giá là đáp ứng một phần theo tiêu chuẩn RECIST 1.1. Sau 9 chu Pemetrexed – Pembrolizumab, bệnh nhân tiếp tục ghi nhận cải thiện rõ rệt các triệu chứng lâm sàng, thể trạng ổn định, không xuất hiện tác dụng không mong muốn nghiêm trọng. Đánh giá trên hình ảnh chụp cắt lớp vi tính cho thấy tổn thương phổi nguyên phát tiếp tục giảm kích thước không ngấm thuốc chỉ còn là đám xơ xẹp vùng đỉnh phổi phải, các hạch trung thất và ngoại vi thu nhỏ rõ rệt, không phát hiện được trên phim chụp và không ghi nhận tổn thương di căn mới.
Một vài nhận xét:
Ở bệnh nhân ung thư phổi không tế bào nhỏ giai đoạn tiến xa không có đột biến gen đích, liệu pháp miễn dịch ức chế điểm kiểm soát miễn dịch phối hợp hóa trị hiện được xem là trụ cột và tiêu chuẩn điều trị bước một, nhờ khả năng cải thiện rõ rệt tỷ lệ đáp ứng, thời gian sống không tiến triển và sống còn toàn bộ. Các nghiên cứu lớn, đặc biệt là KEYNOTE-189, đã chứng minh lợi ích sống còn có ý nghĩa của phác đồ pembrolizumab kết hợp hóa chất nền platinum so với hóa trị đơn thuần, bất kể mức biểu hiện PD-L1.
Trên đây là ca lâm sàng một bệnh nhân ung thư phổi không tế bào nhỏ giai đoạn IV thể biểu mô tuyến, EGFR/ALK âm tính, có biểu hiện PD-L1 cao, thuộc nhóm tiên lượng xấu. Sau khi được điều trị bước một bằng phác đồ pembrolizumab kết hợp hóa chất nền platinum, bệnh nhân đạt đáp ứng điều trị tốt trên lâm sàng và hình ảnh học, với khả năng dung nạp điều trị chấp nhận được và không ghi nhận biến cố bất lợi nghiêm trọng. Việc lựa chọn phác đồ điều trị phù hợp với đặc điểm mô bệnh học và sinh học phân tử của khối u đóng vai trò quan trọng trong việc tối ưu hóa hiệu quả điều trị và hạn chế độc tính cho người bệnh.
Ca lâm sàng tiếp tục khẳng định vai trò quan trọng của liệu pháp miễn dịch kết hợp hóa trị trong điều trị ung thư phổi không tế bào nhỏ giai đoạn tiến xa, không chỉ về hiệu quả kiểm soát bệnh mà còn về ý nghĩa tiên lượng. Điều trị bước một hiệu quả giúp kiểm soát bệnh ngay từ giai đoạn đầu của tiến trình điều trị, tạo điều kiện thuận lợi cho chiến lược điều trị duy trì và theo dõi lâu dài. Bên cạnh đó, kết quả điều trị này cũng nhấn mạnh vai trò của tiếp cận đa chuyên khoa trong cá thể hóa điều trị, nhằm lựa chọn chiến lược tối ưu cho từng bệnh nhân, qua đó góp phần cải thiện chất lượng sống và tiên lượng lâu dài cho bệnh nhân ung thư phổi không tế bào nhỏ.